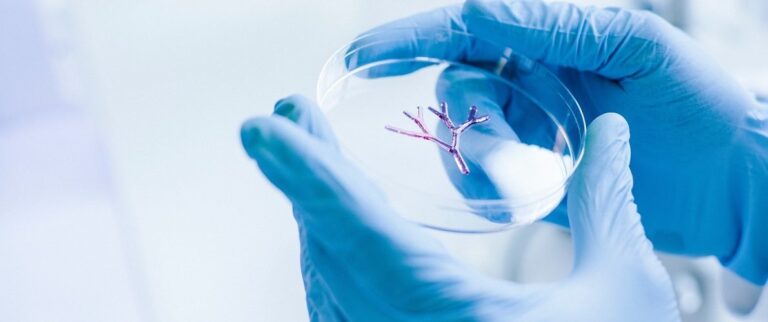
3d bioprinitng future

An insight into applications and future perspectives of 3D bioprinting
Traditional tissue engineering methods showed limited success in the fabrication of complex 3D shapes resulting in non-feasible clinical applications. Over the past decade, 3D bioprinting technology emerged as a powerful tool in the field of…








